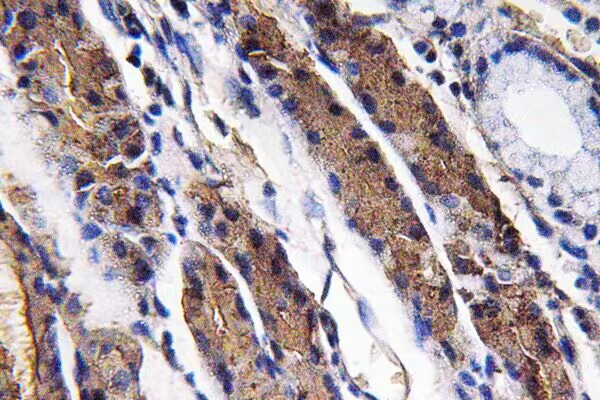

-
分类: 科研抗体货号: P41615别名: dual specificity phosphatase 6, MKP3, PYST1应用: WB,IHC反应种属: Human
-
分类: 科研抗体货号: P41585别名: Dp-1; TFDP1; DRTF1应用: WB反应种属: Human,Mouse
-
分类: 科研抗体货号: P41614别名: calpain, small subunit 1, 30K, CANP, CDPS, CSS1, CANPS, CAPN4, CALPAIN4应用: WB,IHC反应种属: Human,Mouse
-
分类: 科研抗体货号: P41605别名: FBXL1应用: WB反应种属: Human
-
分类: 科研抗体货号: P41613别名: ATP-binding cassette sub-family B member 8, MABC1, M-ABC1, EST328128应用: WB,IHC反应种属: Human
-
分类: 科研抗体货号: P41604别名: KIAA0646应用: WB反应种属: Human
-
分类: 科研抗体货号: P41612别名: Ketohexokinase; Hepatic fructokinase; KHK应用: WB,IHC反应种属: Human
-
分类: 科研抗体货号: P41627别名: Pepsinogen 3, group I (pepsinogen A), PGA4, PGA5应用: WB,IHC反应种属: Human
-
分类: 科研抗体货号: P41611别名: Ketohexokinase; Hepatic fructokinase; KHK应用: WB,IHC反应种属: Human
-
分类: 科研抗体货号: P41626别名: matrix metallopeptidase 8 (neutrophil collagenase), HNC, CLG1, MMP-8, PMNL-CL应用: WB,IHC反应种属: Human

鄂公网安备42018502007531号
鄂公网安备42018502007531号

